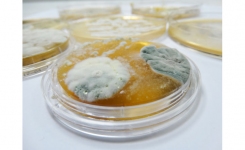
Yeasts and Moulds
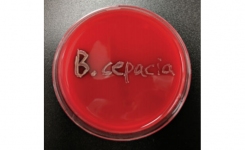
Burkholderia cepacia complex BCC

Lonza’s PyroGene™ recombinant Factor C Assay does not rely on lysate derived from horseshoe crabs and has proven equivalency to LAL-based methods. Therefore, companies can feel confident in implementing rFC methods in their QC testing labs.
News : Feb 2019
View by sector:
Go